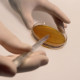
Бактерио&shy;логическая лаборатория

АКТУАЛЬНЫЕ НОВОСТИ!
⚡⚡⚡ С 10.09.2025 в соответствии с постановлением Правительства Ярославской области от 27.05.2025 № 531-п «О реорганизации государственного бюджетного учреждения здравоохранения Ярославской области «Областная детская клиническая больница»», ГБУЗ ЯО «Областная детская клиническая больница» реорганизовано путем присоединения к нему ГБУЗ ЯО «Областной перинатальный центр», ГБУЗ ЯО «Областной врачебно-физкультурный диспансер» и ГУЗ ЯО «ГОРОДСКАЯ ДЕТСКАЯ БОЛЬНИЦА» (г.Рыбинск).
В соответствии с законодательством Российской Федерации в результате реорганизации в форме присоединения правопреемником по всем правам и обязательствам является ГБУЗ ЯО «Областная детская клиническая больница».
Официальный сайт ГБУЗ ЯО "ОДКБ" https://odkb76.gosuslugi.ru/
Официальная группа в ВКонтакт ГБУЗ ЯО "ОДКБ" https://vk.com/odkb76
⚡⚡⚡ ЛИЧНЫЙ ПРИЕМ ГРАЖДАН:
Главный врач ГБУЗ ЯО "Областная детская клиническая больница" Кирдянов Сергей Юрьевич
В рабочие дни понедельник-среда, пятница с 10:00 до 15:00.
Прием граждан осуществляется по адресу: г.Ярославль, Тутаевское ш., д.27 (здание КДЦ ОДКБ, 2 этаж, приемная - кабинет №237).
Телефон приемной: 8(4852)67-98-82
Адрес электронной почты: adm.odkb@yarregion.ru
Руководитель Перинатального центра – главный внештатный специалист по акушерству и гинекологии области Сорокина Татьяна Александровна
В рабочие дни вторник и четверг с 15:00 до 16:00, по адресу Тутаевское ш., д.31В, кабинет №818 (8 этаж), телефон 8(4852)78-81-02.
Бланк Заявления на получение выписок и копий медицинских документов скачать
⚡⚡⚡ ВАЖНО! При поступлении на госпитализацию и роды при себе строго обзязательно иметь: ПАСПОРТ, ПОЛИС ОМС И СНИЛС (с Госуслуг документы не принимаются).
ссылка на рздел нашего сайта - Акушерское физиологическое отделение
⚡⚡⚡ ДОРОДОВАЯ ГОСПИТАЛИЗАЦИЯ
Уважаемые беременные и роженицы!
- Плановая дородовая гоcпитализация в отделение патологии беременности осуществляется в будние дни с 09:00 до 15:00
- Госпитализация в акушерское физиологическое отделение и отделение патологии беременности в выходные дни осуществляется только по экстренным показаниям.
- Решение о наличии экстренных показаний для госпитализации принимается в приемном покое акушерского физиологического отделения.
- При наличии экстренных показаний пациентка будет госпитализирована даже в случае отсутствия мест в отделении на дополнительно организованное место.
⚡⚡⚡ Приглашаем на роды женщин из других регионов по полису ОМС.
Возможна дородовая госпитализация по медицинским показаниями при наличии направления из женской консультации либо на платной основе.
⚡⚡⚡ ШКОЛА БУДУЩИХ МАМ
Приглашаем будущих мам и пап в новую группу - начало занятий - 4 мая ссылка на пост в нашей группе ВКонтакте
Записаться на БЕСПЛАТНЫЕ курсы можно по телефону (4852)78-83-71 с 13:00 до 14:00 ежедневно, кроме выходных и праздничных дней.
Перед занятием необходимо пройти регистрацию в регистратуре на первом этаже, при себе необходимо иметь паспорт и полис ОМС Ярославской области, сменную обувь.
Присутствие на всех лекциях обязательно.
⚡⚡⚡ ПАРТНËРСКИЕ РОДЫ В ПЕРИНАТАЛЬНОМ ЦЕНТРЕ СОВЕРШЕННО БЕСПЛАТНО
Мы придерживаемся политики семейноориентированных родов и поощряем их. Во-первых, это психологическая и эмоциональная поддержка женщины, во-вторых позитивные эмоции у отца, в-третьих - благоприятно сказывается на микрофлоре ребенка.
Согласовывать и предупреждать за ранее никого не нужно. Вы приезжаете на роды и в приемном отделении говорите, что у Вас партнерские роды.
У партнера не должно быть инфекционных заболеваний.
На основании п. 811. Постановления Главного Государственного санитарного врача РФ от 28.01.2021 №4 «Об утверждении санитарных правил и норм СанПиН 3.3686-21 «Санитарно-эпидемиологические требования по профилактике инфекционных болезней» партнёр, присутствующий при партнерских родах, обязан предоставить результат обследования на туберкулез (флюорографию органов грудной клетки) давностью не более 1 года.
Кроме того, партнеру нужно при себе иметь паспорт, сменную обувь (чистые моющиеся тапки/сабо), сменную чистую одежду (футболку и штаны, !!!шорты нельзя), носки, можно пару чистых носовых платков, пачку влажных антибактериальных салфеток и маленькую бутылочку с питьевой водой. Одежда партнера должна соответствовать стерильным условиям родильного отделения. Рекомендуются хлопчатобумажная легкая чистая проглаженная одежда и моющиеся тапочки.
Если партнером на родах является женщина, кроме вышеперечисленного необходимы документы, подтверждающие родство.
⚡⚡⚡ ПОСЕЩЕНИЯ В СТАЦИОНАРАХ ВРЕМЕННО ПРИОСТАНОВЛЕНЫ
С учетом эпидемиологической ситуации в регионе, в настоящее время посещения пациентов, находящихся в стационарах Перинатального центра, временно приостановлены.
Передачи принимаются ежедневно с 16:00 до 19:00 в центральном холле Стационара.
⚡⚡⚡ Диспансеризации граждан репродуктивного возраста по оценке репродуктивного здоровья
В рамках проведения 2 этапа диспансеризации граждан репродуктивного возраста по оценке репродуктивного здоровья пациенты направляются в отделение охраны репродуктивного здоровья ГБУЗ ЯО «Областной перинатальный центр» для проведения диагностического исследования эякулята. Спермограмма – необходимый и доступный вид исследования для оценки состояния репродуктивной системы мужчины: позволяет получить информацию о концентрации, подвижности, строении, жизнеспособности сперматозоидов, а также о наличии или отсутствии воспалительного процесса в органах половой системы мужчин. В лаборатории есть кабинет для сбора эякулята. Мужчины обеспечиваются одноразовым контейнером для биоматериала и бумажными полотенцами.
Подготовка пациента к проведению исследования эякулята:
1. Половое воздержание 3-4 дня, если не назначено врачом иное (допустимо от 2-7 дней).
2. После перенесенной бактериальной, вирусной инфекции ( лечения антибиотиками) необходимо воздержаться от исследования в течение 3 недель.
3. За 3-4 дня до исследования целесообразно исключить баню, сауну, тяжелый физический труд, стрессы, физиопроцедуры (после массажа простаты исследование эякулята следует перенести на 2-3 дня).
4. Ограничение по приему алкогольных напитков.
5. Ночью перед сдачей анализа необходимо обеспечить себе полноценный отдых.
Прием пациентов осуществляется с 11:00 до 13:00 с понедельника по пятницу (при себе иметь паспорт, полис ОМС и направления из медицинской организации, в которой пациент проходил 1 этап диспансеризации. При возникновении вопросов можно звонить в лабораторию отделения охраны репродуктивного здоровья по номеру телефона 8(4852)78-82-05.
⚡⚡⚡ Телефон доверия по вопросам репродуктивного выбора и кризисных состояний 8(4852)78-81-70 психолого-социальная служба
⚡⚡⚡ Вознаграждение за привлечение добровольца на службу возросло до 100 тысяч рублей
 Со дня открытия
60482
Со дня открытия
60482
 С начала года
3003
С начала года
3003
 Мальчиков
1586
Мальчиков
1586
 Девочек
1417
Девочек
1417

.jpg)









